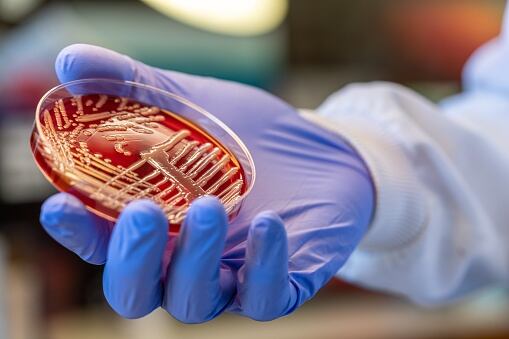
Klebsiella

El Hospital San Rafael de Tunja a través de sus redes sociales hicieron un anuncio importante en cuanto a una bacteria que está rondando en los hospitales del país, esta bacteria se llama “Klebsiella” y es productora de Carbapenemasas.
El gerente, Dr. Germán Pertuz, fue el encargado de hacer dicho anuncio en el que señala que esta bacteria “está circulando en los diferentes hospitales del país”.

“Esta bacteria no es del Hospital San Rafael de Tunja, se trata de una enterobacteria que está en muchos hospitales, gracias al trabajo de epidemiología podríamos decir que somos la única institución en salud que está haciendo tamizaje para la bacteria e identificado los casos”, señaló Germán.
Al tiempo el gerente manifestó que reciben pacientes de todos los hospitales del departamento de Boyacá y “también queremos aclarar que en estos momentos el brote de Klebsiella no es solamente en Boyacá, tenemos brote en Bogotá, en el Valle del Cauca, y en la Costa Atlántica”.
#Anuncio 📣
— Hospital San Rafael de Tunja (@HSanRafaelTunja) October 4, 2023
El equipo especialista del San Rafa, en cabeza del gerente, Dr. Germán Pertuz, hacen un anuncio oficial sobre la bacteria Klebsiella productora de Carbapenemasas, que está circulando en los diferentes hospitales del país.
Toda la información 👇🏻 pic.twitter.com/bcs5lf31Mc
¿Qué es la bacteria Klebsiella?
De acuerdo a la información que brinda la Organización Mundial de la Salud, “La Klebsiella pneumoniae es una bacteria intestinal común que puede provocar infecciones potencialmente mortales.”

La resistencia de esta bacteria al tratamiento de último recurso (los antibióticos carbapenémicos) se ha propagado a todas las regiones del mundo, según la OMS.
Infecciones
La Klebsiella pneumoniae es una importante causa de infecciones nosocomiales, como la neumonía, las septicemias o las infecciones de los recién nacidos y los pacientes ingresados en unidades de cuidados intensivos. En algunos países, “los antibióticos carbapenémicos ya no son eficaces en más de la mitad de los pacientes con infecciones por K. pneumoniae debido a la resistencia”.

¿Cuándo es peligrosa?
De acuerdo a Medicina y Salud Pública (MSP), esa bacteria resulta peligrosa fuera del intestino. “Si llega a otras partes del organismo humano, puede causar infecciones. Normalmente, provocan neumonía, sepsis, infecciones en heridas y en el tracto urinario. Si no se pueden controlar, esas infecciones pueden causar la muerte del enfermo”.
¿Cómo se contagia?
Esta bacteria suele transmitirse por contacto con la piel, mucosas, heces, heridas u orina de una persona infectada, el instituto de medicina señala que también suele transmitirse a través del “contacto con materiales que han quedado contaminados como catéteres, sondas o ventilación asistida o la superficie de quirófanos”.

¿Qué enfermedades causa?
Su actividad, que puede generar neumonía, sepsis u otros tipos de infecciones, se ha cobrado vidas humanas tanto a nivel nacional como internacional.
“En el exterior, una mujer falleció en Estados Unidos. Tras habérsele realizado una serie de pruebas, se decretó que la superbacteria era resistente a 26 tipos de antibióticos”.
¿A qué pacientes afecta?
MSP detalla que muchas personas son portadoras, es decir, llevan la bacteria sin que les produzca infección, a partir de ahí, siempre tienen más riesgo de desarrollar la infección o de contagiarse los pacientes inmunosuprimidos donde la bacteria puede progresar y generar infección.
“Son especialmente susceptibles a ella los pacientes ingresados en unidades de cuidados intensivos, neonatos, pacientes con enfermedad pulmonar obstructiva crónica, diabéticos o alcohólicos. Se trata de pacientes con alteraciones de las defensas orgánicas”.
Cómo se detecta y se trata la infección
De acuerdo a la fuente citada, para poder comprobar si un paciente ha desarrollado la infección se deben obtener muestras de las mucosas de la cavidad bucal y nasal, del tracto respiratorio superior (faringe y laringe), orina, sangre u otros tejidos infectados, y someter la muestra a una tinción de Gram para identificar la bacteria, que muestra un tono rosado suave.
“Respecto al tratamiento, se basa en la administración de antibióticos por vía intravenosa, y si la infección se ha contraído fuera del ámbito hospitalario, puede curarse con cefalosporinas o fluoro quinolonas, aunque en el caso de que se haya adquirido en el hospital la bacteria suele ser resistente a estos medicamentos”.
